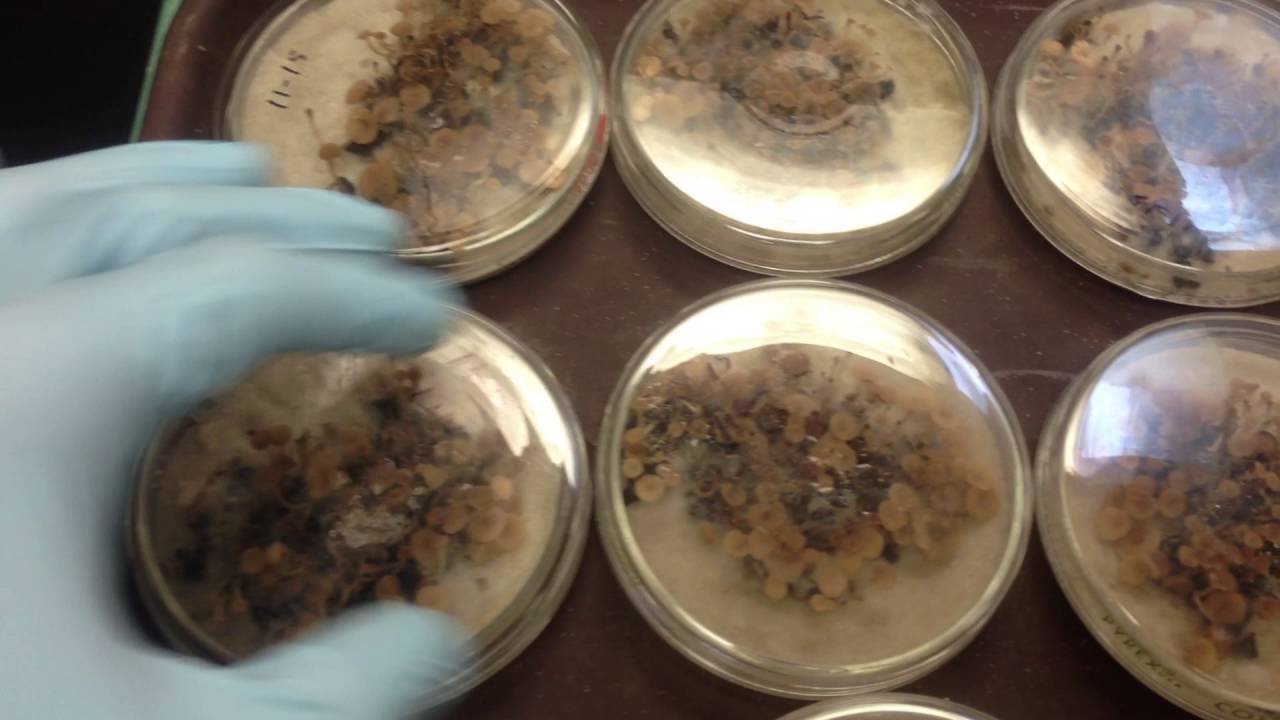
White Mold (Sclerotinia sclerotiorum)

Видео с ютуба Sclerotinia

Sclerotinia - Agente causal del Moho blanco

Odmiany Rzepaku Pioneer® Protector Sclerotinia (PT303 i PT312)

Sclerotinia Sclerotiorum Ep. 1/3🌻Root System, Sunflower Putregaiul alb de radacina Floarea-soarelui

Rzepaki odporne na Verticillium, Sclerotinia i Phoma? Kiedy? | Zapytaj Profesora
White Mold (Sclerotinia sclerotiorum)

R191 Extractos etanólicos sobre Sclerotinia

🔎 LALEXPERT: Sclerotinia cycle and prophylactic methods

White mold disease | Sclerotinia sclerotiorum

BIOLAPSE - timelapse Sclerotinia sclerotiorum

Sclerotinia tolerance by HelioSMART | MAS Seeds

What is Sclerotinia and when should growers be concerned about it?

Sclerotinia White Mold #1085 (Air Date 1-20-19)

How to Identify Sclerotinia in OSR

Sclerotinia sclerotiorum Fungal Spores Dispersal Movie S1

Canola Fungicides: Become a Sclerotinia Specialist

Sclerotinia: Spring Disease that Disappears in Summer

White Mold - Sclerotinia Stem Rot

Canola School: Short-and long-term management options for sclerotinia

CREC Michael Wunsch: Susceptibility of Sunflowers to Sclerotinia Head Rot Relative to Growth Stage

Pioneer Protector Sclerotinia Tolerance Trait Mode of Action